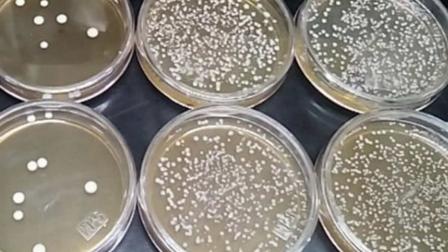
thumb

Encapsulan café y lo enriquecen con probióticos
Coadyuva en la regeneración de la flora intestinal, minimice problemas gástricos y potencie la capacidad de aprovechamiento de los nutrientes
Como apoyo a productores cafetaleros de la Sierra Nororiental de Puebla, mediante alternativas que generen valor al café, investigadores del Instituto Politécnico Nacional (IPN) elaboraron encapsulados de extracto líquido de café con un plus saludable al incorporar microorganismos probióticos como Lactobacillus plantarum.
Durante años, científicos del Centro de Investigación en Biotecnología Aplicada (CIBA), ubicado en Tlaxcala, encabezados por la Maestra en Ciencias, Minerva Rosas Morales, han realizado estudios para generar diversos insumos con base en este grano, con la idea de diversificar de manera innovadora la oferta de bebidas a base de café.
La Maestra Rosas Morales indicó que Lactobacillus plantarum es una bacteria identificada como probiótica y productora de bacteriocinas, la cual tiene la habilidad de sobrevivir al tránsito gástrico, con beneficio para el sistema inmune, mejora la salud del tracto gastrointestinal y coadyuva en la biodisponibilidad de los nutrientes para el consumidor, además de otras importantes funciones.
Sostuvo que, para generar un producto altamente competitivo en calidad, han evaluado aspectos importantes sobre el origen del grano, tueste, granulometría y métodos de extracción.
El aporte sustancial estriba en la incorporación de un elemento con actividad probiótica que no modifica en absoluto las características organolépticas del café concentrado”, aclaró.
La investigadora explicó que la encapsulación constituye un proceso aplicado para proteger, mediante un material de recubrimiento o material pared, la estabilidad, biodisponibilidad y conservación de los componentes bioactivos y mantener la viabilidad de los microorganismos.
Aunque no estamos en la fase de comercialización consideramos que se han sentado las bases para escalarse a nivel semi-industrial, tenemos el vínculo con productores que participan en toda la cadena productiva y comercializan sus productos en una red de tiendas que se convertirán en el canal de prueba para llevar el producto a los consumidores”, refirió.
La Maestra Rosas Morales indicó que este proyecto está en una fase para asegurar que el producto mantenga su viabilidad en el organismo humano; es decir, que coadyuve en la regeneración de la flora intestinal, minimice problemas gástricos y potencie la capacidad de aprovechamiento de los nutrientes.
Finalmente, comentó que trabaja en generar una patente que pueda ser transferible, pero sobre todo espera que esta investigación siente las bases para explorar nuevos mercados y se escale a una producción semi-industrial para el beneficio de las comunidades productoras de café.
asc